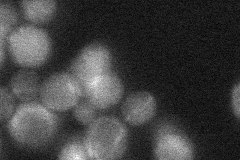
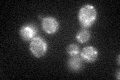
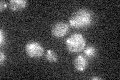

View description
DNA-binding protein of the mitochondria involved in repair of mitochondrial DNA, has ATPase activity and binds to DNA mismatches; has homology to E. coli MutS; transcription is induced during meiosis
Localization:
Intensity:
Fold change:
Significance:
-
C’ GFP library in SD

mitochondria21.35 -
N' NOP1pr-GFP in SD

mitochondria54.8966 -
N' TEF2pr-mCherry in SD

mitochondria63.9162 -
N' NATIVEpr-GFP in SD
mitochondria23.8998 -
N' TEF2pr-VC and Cyto-VN in SD

#N/A0 -
C’ GFP library in SD+DTT
mitochondria21.150.99No -
C’ GFP library in SD+H2O2

mitochondria21.821.02No -
C’ GFP library in Starvation Media
mitochondria19.570.91No -
C’ GFP library on the background of Pup2-DaMP

mitochondria -
C’ GFP library on the background of CCT mutant

mitochondria24.04251.12564No
